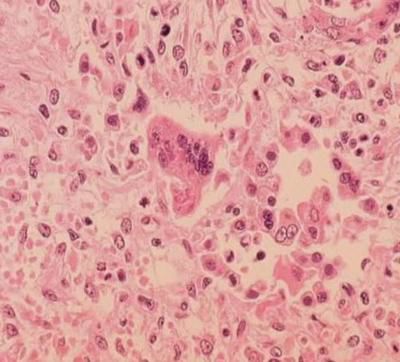

Illinois men's basketball opens up its two-game business trip to Los Angeles against USC Wednesday night.
Flames rise from the Chevron refinery in El Segundo, Calif., Thursday, Oct. 2, 2025. (AP Photo/Ethan Swope)
LOS ANGELES (WAND) – A wild police chase came to an end, when deputies had to tackle the driver to the ground in the middle of a busy Southern…
PHILADELPHIA (WAND) - The jersey that late NBA legend Kobe Bryant wore while playing at his Philadelphia high school has been returned after i…
People all across the world mourn the loss of Kobe Bryant after a helicopter leaves him and eight others, including his daughter Gianna, dead.
LOS ANGELES (WAND) - Three more cases of Coronavirus have been diagnosed in the U.S., bringing the national total to five.
LOS ANGELES, Calif. (WAND) – In the middle of California’s Getty Fire last week, firefighters say they found a wedding ring in the gutter of a…
LOS ANGELES, Ca. (WAND) - Health officials in Los Angeles are warning anyone who traveled through LAX of a possible measles exposure.